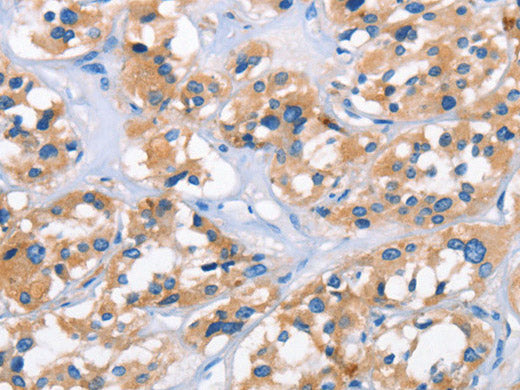
APOL6 Polyclonal Antibody Store at -20°C

APOL6 Polyclonal Antibody Store at -20°C
Couldn't load pickup availability

Still have questions? Ask our experts!
APOL6 Polyclonal Antibody Store at -20°C
| SKU # | E-AB-13077 |
| Reactivity | Human |
| Host | Rabbit |
| Applications | IHC |
Product Details
| Isotype | IgG |
| Host | Rabbit |
| Reactivity | Human |
| Applications | IHC |
| Clonality | Polyclonal |
| Immunogen | Synthetic peptide of human APOL6 |
| Abbre | APOL6 |
| Synonyms | 2310076O14Rik, 6, APOL VI, APOL6, APOLVI, ApoL-VI, Apolipoprotein L, Apolipoprotein L VI, Apolipoprotein L-VI, Apolipoprotein L6, DKFZp667M075, FLJ38562, FLJ90164, MGC57495 |
| Swissprot | |
| Cellular Localization | Cytoplasm. |
| Concentration | 0.6 mg/mL |
| Buffer | Phosphate buffered solution, pH 7.4, containing 0.05% stabilizer and 50% glycerol. |
| Purification Method | Affinity purification |
| Research Areas | Cancer, Cell Biology, Cardiovascular, Metabolism |
| Conjugation | Unconjugated |
| Storage | Store at -20°C Valid for 12 months. Avoid freeze / thaw cycles. |
| Shipping | The product is shipped with ice pack,upon receipt,store it immediately at the temperature recommended. |
Related Reagents
| Applications | Recommended Dilution |
| IHC | 1:25-1:200 |
Background
This gene is a member of the apolipoprotein L gene family. The encoded protein is found in the cytoplasm, where it may affect the movement of lipids or allow the binding of lipids to organelles. Widely expressed; highly expressed in the uterus, fetal brain and spinal cord, also detected in heart, liver, lung, colon, spleen, thymus, prostate, placenta, adrenal gland, salivary and mammary gland.